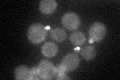
YMR192W
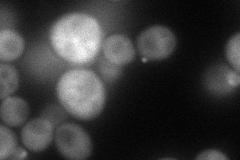
YMR192W
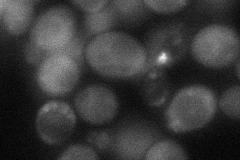
YMR192W
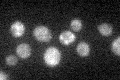
YMR192W

View description
Putative GTPase activating protein (GAP) that may have a role in polarized exocytosis; stimulates Gyp5p GAP activity on Ypt1p, colocalizes with Gyp5p at sites of polarized growth; interacts with Gyp5p, Rvs161p, and Rvs167p
Localization:
Intensity:
Fold change:
Significance:
-
C’ GFP library in SD
bud neckN/A -
N' NOP1pr-GFP in SD

cytosol,bud58.8094 -
N' TEF2pr-mCherry in SD
cytosol,bud71.911 -
N' NATIVEpr-GFP in SD

punctate,bud22.1727 -
N' TEF2pr-VC and Cyto-VN in SD
cytosol,bud48.7577 -
C’ GFP library in SD+DTT

bud neckN/AN/ANo -
C’ GFP library in SD+H2O2

bud neckN/AN/ANo -
C’ GFP library in Starvation Media
cytosol31.970.99No -
C’ GFP library on the background of Pup2-DaMP

bud neck -
C’ GFP library on the background of CCT mutant

bud neck28.63890.893928No
